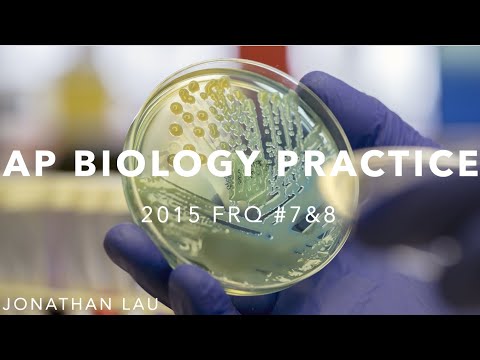
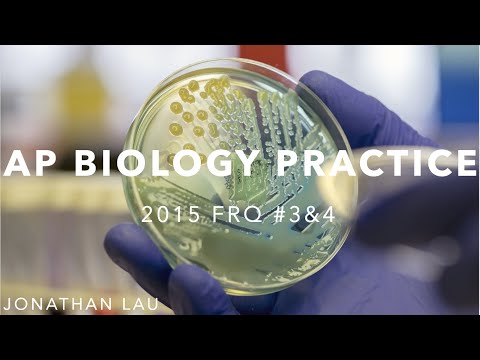
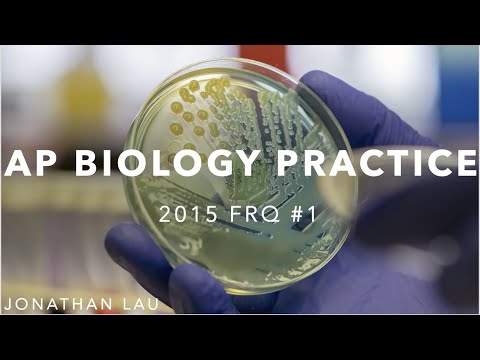

EDD Academy
How to Get Into Northwestern Biomedical Engineering!
14:58

EDD Academy
SAT Official Test #10: Math No Calculator (Q11-20)
16:43

EDD Academy
AP Chemistry: 2014 Free Response #1
8:34

EDD Academy
2019 AP World History Short Answer 1
22:31

EDD Academy
AP US History Lesson 1: Native Americans Before European Contact
8:13

EDD Academy
Music Theory: Circle of Fifths
5:05

EDD Academy
SAT Official Test #10: Math No Calc (Q1-10)
16:37

EDD Academy
AP Biology Practice: 2013 FRQ 5-8
9:45

EDD Academy
AP Biology Practice: 2013 FRQ 1-4
15:24

EDD Academy
Exponential Models with Differential Equations
4:48

EDD Academy
Calculus 2 - Sequences and Series Review
11:29

EDD Academy
Differential Equations Review
11:46

EDD Academy
Verifying Solutions of Differential Equations
6:32

EDD Academy
Riemann Sum Example
3:48

EDD Academy
Introduction to Riemann Sums
7:21

EDD Academy
AP Biology Practice: 2014 FRQ 5-8
11:08

EDD Academy
AP Biology Practice: 2014 FRQ 1-4
18:23
EDD Academy
AP Biology Practice: 2015 FRQ 7&8
8:20

EDD Academy
AP Biology Practice: 2015 FRQ 5&6
7:38
EDD Academy
AP Biology Practice: 2015 FRQ 3&4
9:02

EDD Academy
AP Biology Practice: 2015 FRQ 2
9:32

EDD Academy
Unit 6 Lesson 3: U-Substitution
6:10
EDD Academy
AP Biology Practice: 2015 FRQ 1
8:39

EDD Academy
2019 MIT Integration Bee #18
5:29

EDD Academy
2019 MIT Integration Bee #4
6:23

EDD Academy
Unit 8 Lesson 2.5: Finding the Area Between Curves (Functions of Y)
4:06

EDD Academy
Unit 6 Lesson 2: Indefinite Integration
5:13

EDD Academy
Python For Kids: The Basics
10:18

EDD Academy
SAT Official Test #5: Math - No Calculator Section Walkthrough Part 1
19:13

EDD Academy
Introduction To Biology: Heredity
32:29

EDD Academy
Introduction to Biology: Evolution
19:18

EDD Academy
SAT Official Test #1: Math No Calc Section (#10-20)
20:04

EDD Academy
UIUC CS: Interviewing an Admitted Student!
11:21

EDD Academy
Introduction to Biology: Photosynthesis
11:30

EDD Academy
Introduction to Biology: Cellular Respiration
20:42

EDD Academy
Introduction to Biology: Enzymes
24:28

EDD Academy
Unit 8 Lesson 2: Finding the Area Between Curves (Functions of X)
7:47

EDD Academy
Unit 8 Lesson 1: Average Value of a Function
9:19

EDD Academy
Unit 3 Lesson 5: Combining Rules Practice
13:00

EDD Academy
Introduction to Biology: Mitosis
12:05

EDD Academy
Introduction to Biology: Cell Structure
29:14

EDD Academy
SAT Official Test #3: Math - No Calculator Section Walkthrough Part 2
32:22

EDD Academy
SAT Official Test #3: Math - No Calculator Section Walkthrough Part 1
17:07

EDD Academy
Unit 3 Lesson 4: Memorizing Trig and Inverse Trig Derivatives
18:13

EDD Academy
Unit 7 Lesson 1: Modeling Solutions with Differential Equations
8:50

EDD Academy
Introduction to Biology: Basic Biochemistry
22:11

EDD Academy
Unit 4 Lesson 5: L'Hopital's Rule
15:37

EDD Academy
Unit 4 Lesson 4: Differentials (Local Linearity)
9:00

EDD Academy
Unit 2 Lesson 7: Other Trig Derivatives
13:30

EDD Academy
Unit 2 Lesson 5: Product Rule
7:57

EDD Academy
Unit 2 Lesson 4: Differentiation of Exponential and Logarithmic Functions
13:33

EDD Academy
Unit 2 Lesson 3: Finding Derivatives of Sin and Cos Functions
15:33

EDD Academy
Unit 1 Lesson 3: Limit Laws
7:02

EDD Academy
Unit 4 Lesson 3: Related Rates cont.
12:59

EDD Academy
Unit 3 Lesson 2: Implicit Differentiation
14:16

EDD Academy
Unit 1 Lesson 2: Continuity
6:45

EDD Academy
Unit 2 Lesson 2: Basic Differentiation Rules Continued
13:45

EDD Academy
SAT Official Test #2: Math - No Calculator Section Walkthrough
25:52

EDD Academy
Unit 4 Lesson 2: Related Rates
9:24

EDD Academy
Unit 2 Lesson 1: Basic Differentiation Rules
8:03

EDD Academy
Unit 1 Lesson 1: Defining Limits
5:06

EDD Academy
Unit 4 Lesson 1: Motion Along a Line
16:13